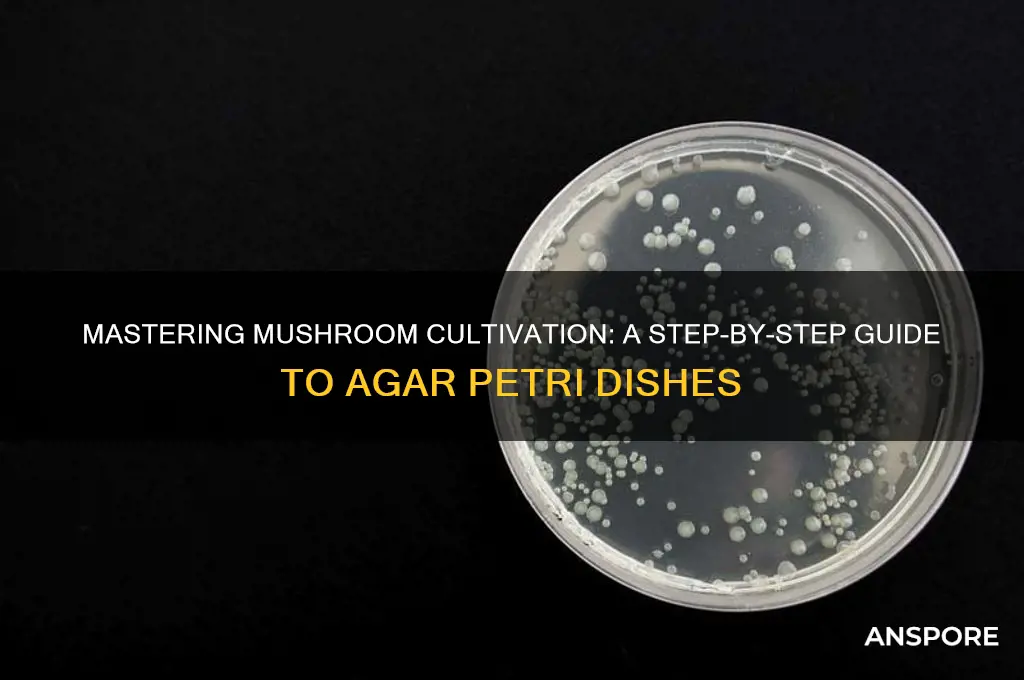
how to make agar petri dishes for mushrooms

Creating agar petri dishes is a fundamental technique in mushroom cultivation, providing a sterile environment for mycelium to grow and thrive. This method involves preparing a nutrient-rich agar medium, sterilizing it to eliminate contaminants, and then inoculating it with mushroom spores or mycelium. The process begins by mixing agar powder with water and a carbohydrate source, such as sugar or malt extract, to create a gel-like substrate. The mixture is then sterilized using an autoclave or pressure cooker to ensure it is free from bacteria, fungi, and other microorganisms. Once cooled, the agar is poured into petri dishes and allowed to solidify. Finally, the dishes are inoculated under sterile conditions, often using a laminar flow hood or glove box, to prevent contamination. This setup allows cultivators to observe mycelial growth and isolate healthy cultures for further propagation, making it an essential step in successful mushroom cultivation.
Explore related products
What You'll Learn
- Sterilize agar mixture using an autoclave or pressure cooker for 30-60 minutes
- Prepare substrate with nutrients like malt extract, dextrose, and peptone
- Pour agar into Petri dishes in a sterile environment to avoid contamination
- Inoculate dishes with mushroom mycelium using a sterile inoculation loop or needle
- Incubate dishes at optimal temperature (22-28°C) in a dark, clean space

Sterilize agar mixture using an autoclave or pressure cooker for 30-60 minutes
Sterilizing the agar mixture is a critical step in preparing petri dishes for mushroom cultivation, as it ensures that no contaminants interfere with the growth of your mushroom mycelium. To achieve proper sterilization, you can use either an autoclave or a pressure cooker, both of which are effective at eliminating bacteria, fungi, and other microorganisms. The process involves subjecting the agar mixture to high temperatures and pressure for 30 to 60 minutes, depending on the equipment and volume of the mixture. Begin by transferring the prepared agar solution into sterile containers, such as glass jars or flasks, ensuring they are only filled halfway to allow for expansion during sterilization. Seal the containers with cotton plugs or aluminum foil to prevent contamination while still allowing steam to escape.
If using an autoclave, place the containers inside the chamber, ensuring they are not overcrowded to allow proper steam circulation. Set the autoclave to run at 121°C (250°F) and 15 psi for 30 to 60 minutes, depending on the volume of the agar mixture. For smaller volumes, 30 minutes is typically sufficient, while larger batches may require the full 60 minutes. Once the cycle is complete, allow the autoclave to depressurize naturally before opening it to avoid damaging the agar or risking contamination. The agar should appear clear and free of bubbles after sterilization.
For those without access to an autoclave, a pressure cooker can be used as an alternative. Place the sealed containers on a rack inside the pressure cooker, ensuring they do not touch the bottom or each other. Add enough water to the cooker to reach just below the rack, typically about 1 inch of water. Secure the lid and bring the cooker to 15 psi, maintaining this pressure for 30 to 60 minutes. Monitor the pressure gauge carefully to ensure it remains consistent throughout the process. After the sterilization time has elapsed, allow the pressure cooker to cool naturally and depressurize before opening it.
Regardless of the method used, it is essential to handle the sterilized agar with care to avoid recontamination. Allow the containers to cool to a safe temperature before transferring the agar into sterile petri dishes under a laminar flow hood or still air box. Work quickly and methodically to minimize exposure to airborne contaminants. Proper sterilization ensures that the agar provides a clean, nutrient-rich environment for mushroom mycelium to thrive, setting the foundation for successful cultivation.
Always follow safety precautions when using an autoclave or pressure cooker, such as wearing heat-resistant gloves and ensuring the equipment is in good working condition. Improper use can lead to accidents or incomplete sterilization, compromising your entire project. By dedicating time and attention to this step, you significantly increase the chances of successfully growing mushrooms from your agar petri dishes.
Crafting a Cute Mushroom Plush: Step-by-Step DIY Guide
You may want to see also

Prepare substrate with nutrients like malt extract, dextrose, and peptone
To prepare a nutrient-rich substrate for agar petri dishes suitable for mushroom cultivation, start by gathering your ingredients: malt extract, dextrose, peptone, and agar powder. These components provide essential carbohydrates, nitrogen, and structural support for fungal growth. Begin by measuring out the required quantities based on your recipe or standard formulations, such as 20 grams of malt extract, 20 grams of dextrose, 10 grams of peptone, and 15 grams of agar per liter of water. Precision in measurement is crucial to ensure the substrate supports optimal mushroom mycelium development.
Next, combine the dry ingredients in a heat-resistant container. Pour distilled or boiled water into the mixture, stirring continuously to prevent clumping. Distilled water is preferred to avoid contaminants that may interfere with fungal growth. Ensure all components are fully dissolved before proceeding. Heat the mixture on a stove or hotplate, maintaining a gentle simmer. Stir frequently to prevent the solution from sticking to the bottom of the container or burning, as this can alter the substrate's composition and effectiveness.
Once the solution reaches a boil, reduce the heat to a low simmer and allow it to cook for approximately 5–10 minutes. This step ensures the agar is fully activated and the nutrients are evenly distributed. Keep stirring occasionally to maintain a uniform consistency. The mixture should become slightly thickened but still pourable, indicating the agar has dissolved completely. If lumps persist, continue heating and stirring until they dissolve.
After the substrate solution is ready, carefully pour it into sterilized petri dishes. Work in a clean, sterile environment, such as a still air box or laminar flow hood, to minimize contamination. Fill each dish to about 3–4 mm in depth, ensuring a smooth, even surface. Allow the dishes to cool and solidify at room temperature, which typically takes 30–60 minutes. Once solidified, the agar plates are ready for inoculation with mushroom spawn or spores.
Finally, store the prepared petri dishes in a cool, dark place until use. Properly made agar plates can last several weeks if kept sealed and sterile. Label each dish with the date and substrate composition for easy reference. This nutrient-rich substrate, fortified with malt extract, dextrose, and peptone, provides an ideal environment for mushroom mycelium to thrive, setting the stage for successful cultivation.
Rich & Savory Worcester Mushroom Gravy: A Step-by-Step Recipe Guide
You may want to see also

Pour agar into Petri dishes in a sterile environment to avoid contamination
Pouring agar into Petri dishes in a sterile environment is a critical step in creating a contamination-free medium for mushroom cultivation. Begin by preparing your workspace to ensure it is as clean as possible. Wipe down all surfaces with a disinfectant, such as 70% isopropyl alcohol, and allow them to dry completely. Set up your equipment, including the agar solution, Petri dishes, and a Bunsen burner or alcohol lamp, in a designated area away from potential contaminants like open windows or high-traffic areas. It’s also advisable to wear sterile gloves and a face mask to minimize the introduction of airborne particles or skin cells.
Once your workspace is prepared, sterilize the Petri dishes by autoclaving them or using a pressure cooker if you’re working at home. Ensure the dishes are dry before use, as moisture can interfere with the agar’s solidification process. Next, heat the agar solution to the appropriate temperature, typically around 85–90°C (185–194°F), to ensure it remains liquid but is free of microorganisms. Use a magnetic stirrer or gently swirl the container to maintain an even temperature and prevent the agar from burning or sticking to the bottom.
With your agar solution ready, ignite the Bunsen burner or alcohol lamp to create a sterile flame. This flame will act as a barrier to prevent airborne contaminants from settling into the Petri dishes or agar solution. Hold the lid of each Petri dish slightly ajar and pass the opening through the flame to sterilize it. Quickly pour the agar into the dish, ensuring the lid remains in the flame’s path to maintain sterility. Aim to fill each dish about 3–4 mm deep, avoiding overfilling, which can lead to spillage or uneven surfaces.
After pouring, close the Petri dish lid immediately and allow the agar to solidify at room temperature. Work efficiently but calmly, as prolonged exposure to the environment increases the risk of contamination. If you’re pouring multiple dishes, keep the agar solution warm on a heating plate or hotplate set to a low temperature to prevent it from solidifying prematurely. Always maintain the sterile flame throughout the process, especially when handling the lids and pouring the agar.
Finally, once all dishes are filled and the agar has solidified, store them in a clean, dark, and cool environment until you’re ready to inoculate them with mushroom spores or mycelium. Proper labeling with the date and agar type is essential for tracking and organization. By following these steps meticulously, you significantly reduce the risk of contamination, ensuring a successful and healthy mushroom cultivation process.
Creamy Matar Mushroom Recipe: Easy Steps for Rich, Flavorful Delight
You may want to see also
Explore related products

Inoculate dishes with mushroom mycelium using a sterile inoculation loop or needle
To inoculate your prepared agar Petri dishes with mushroom mycelium, begin by ensuring your workspace is sterile to minimize contamination. Use a laminar flow hood or a still air box if available, and sterilize your hands and tools with 70% isopropyl alcohol. Your inoculation loop or needle should be flame-sterilized by passing it through a Bunsen burner flame until it glows red-hot, then allowed to cool momentarily before use. This ensures that no contaminants are introduced to the agar or the mycelium.
Next, carefully remove the lid of the agar Petri dish just enough to access the surface, keeping the opening minimal to reduce exposure to airborne contaminants. If using a sterile inoculation loop, gently press it into the mushroom mycelium source, such as a spore print or existing mycelium culture, to collect a small sample. For a needle, carefully scrape or pick up a tiny piece of mycelium. Ensure the amount is minimal, as a small inoculum is sufficient for the mycelium to grow and colonize the agar.
With your inoculation tool loaded, swiftly but gently streak the mycelium onto the surface of the agar in a zigzag pattern or a single line. Avoid pressing too hard, as this can damage the agar surface. The goal is to create a thin, even distribution of mycelium that will allow for healthy growth. After inoculating, immediately close the Petri dish lid to maintain sterility and prevent contamination.
If you are using multiple dishes, repeat the process for each one, flame-sterilizing your inoculation loop or needle between each use to ensure no cross-contamination occurs. Label each dish with the date and the type of mushroom mycelium used for future reference. Proper labeling is crucial for tracking growth and identifying successful cultures.
Finally, place the inoculated Petri dishes in a clean, dark environment with a stable temperature, typically around 22-25°C (72-77°F), to encourage mycelium growth. Inspect the dishes regularly for signs of contamination or mycelial growth. Healthy mycelium will appear as white, thread-like structures spreading across the agar surface. If contamination is detected, isolate the affected dish to prevent it from spreading to others. With patience and care, your inoculated agar Petri dishes will serve as a foundation for cultivating mushroom mycelium for further propagation or study.
Crispy Dry Mushroom Manchurian Recipe: Easy Step-by-Step Guide
You may want to see also

Incubate dishes at optimal temperature (22-28°C) in a dark, clean space
Once your agar petri dishes are prepared and inoculated with mushroom spawn, the next critical step is incubation. Incubating the dishes at the optimal temperature range of 22–28°C (72–82°F) in a dark, clean space is essential for mycelium growth. This temperature range mimics the natural environment where mushrooms thrive, encouraging healthy and efficient colonization of the agar. Avoid temperatures below 20°C or above 30°C, as they can slow down growth or stress the mycelium. Use a thermometer to monitor the incubation area and ensure consistency. Fluctuations in temperature can hinder growth, so consider using a dedicated incubator or a well-regulated space like a closet or cabinet with a heating pad or thermostat-controlled device.
The incubation space must also be dark, as light can disrupt the mycelium's growth patterns and potentially lead to contamination. Cover the petri dishes with a light-blocking material, such as aluminum foil or a dark cloth, or store them in a closed container or box. Ensure the area is free from direct sunlight or artificial light sources. Darkness promotes focused, even growth of the mycelium, preventing it from wasting energy on light-induced responses.
Cleanliness is paramount during incubation to prevent contamination from bacteria, mold, or other fungi. Before placing the petri dishes in the incubation area, thoroughly clean the space with a disinfectant, such as a 10% bleach solution or alcohol. Allow the area to dry completely to avoid introducing moisture that could encourage contaminants. Keep the incubation space closed as much as possible to minimize exposure to airborne particles. If using a container or box, ensure it is also cleaned and dried before use.
During incubation, minimize disturbances to the petri dishes. Avoid frequent handling or moving them, as this can introduce contaminants or disrupt the mycelium's growth. Check the dishes periodically for signs of colonization, but do so quickly and in a clean manner. If using gloves, ensure they are sterile or freshly cleaned to prevent transferring unwanted organisms. Patience is key, as mycelium growth can take anywhere from a few days to several weeks, depending on the mushroom species and conditions.
Finally, maintain proper airflow in the incubation space to prevent the buildup of excess moisture, which can lead to contamination. Avoid sealing the petri dishes in airtight containers, as this can create a humid environment conducive to mold growth. Instead, use containers with small vents or cracks to allow for air exchange while keeping out dust and debris. Regularly inspect the dishes for any signs of contamination, such as unusual colors or textures, and remove any affected dishes immediately to protect the others. With the right temperature, darkness, and cleanliness, your agar petri dishes will provide a strong foundation for mushroom cultivation.
Crafting Mushroom Dough: Simple Steps for Savory, Earthy Creations
You may want to see also
Frequently asked questions
You will need agar powder, distilled water, petri dishes, a pressure cooker or autoclave, a magnetic stirrer or whisk, a microwave or stove, and a sterile workspace. Additionally, you’ll require a spore or culture syringe for inoculation.
Prepare the agar solution by mixing agar powder with distilled water, then pour it into the petri dishes. Seal the dishes with parafilm or tape, and sterilize them in a pressure cooker or autoclave at 15 psi for 30–45 minutes. Allow to cool before inoculating.
Once the agar has solidified and cooled, use a sterile technique to open the petri dish in a clean, laminar flow hood or still air box. Inject a small amount of spore or culture solution into the agar using a sterile syringe. Seal the dish again and incubate at the appropriate temperature for your mushroom species.

























